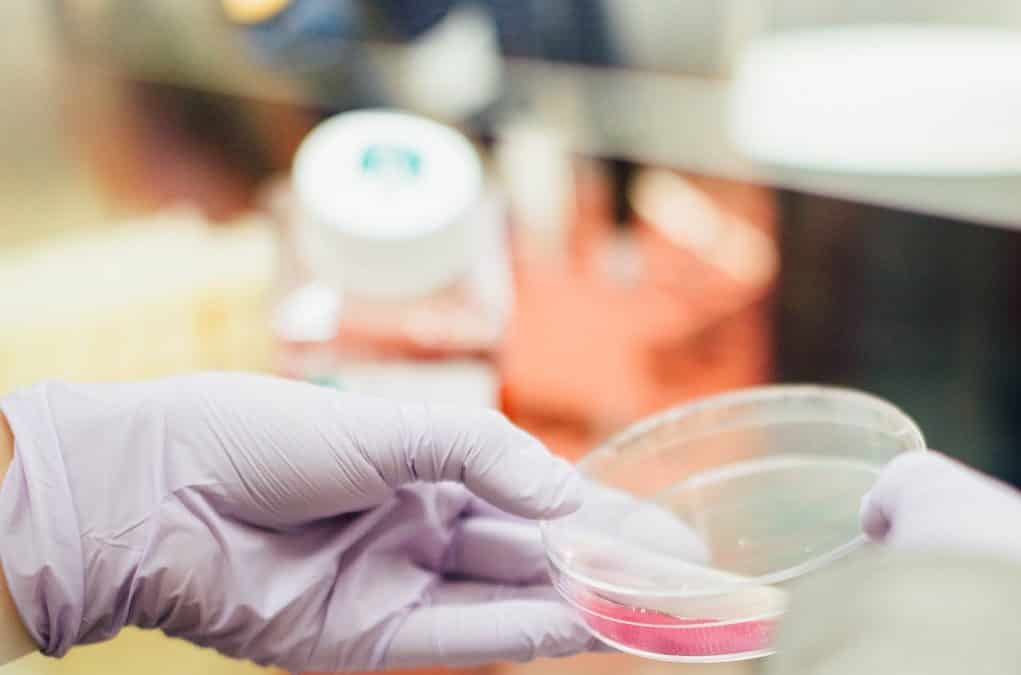
Open letter supporting Italy’s proposed resolution on improving transparency of markets for drugs, vaccines and other health-related technologies

by European Public Health Alliance | May 17, 2019 | Statements
May 17, 2019 RE: Request to start an investigation into the factors leading to medicines shortages Dear Commissioner Andriukaitis, Dear Ms Bucher, Recent studies, such as the 2018 Medicines Shortages Survey of the European Association of Hospital Pharmacists (EAHP)...

by European Public Health Alliance | Mar 12, 2019 | Statements
Over 60 civil society orgqnisations have joined forces to call for the immediate and complete removal of the “innovation principle” from Horizon Europe, the next EU Framework Programme for Research and Innovation. Supporters of the call believes the innovation...

by European Public Health Alliance | Mar 6, 2019 | Statements
To: WHO Member States On 1 February 2019, Italy submitted a draft resolution on transparency to the World Health Organization (WHO). This resolution is to be discussed in May 2019, at the 72nd session of the World Health Assembly (WHA). The title of the proposed...

by European Public Health Alliance | Feb 4, 2019 | Opinion
Here are the top 5 EU medicines policy issues which will dominate the agenda in 2019. DOWNLOAD THE ARTICLE 1. The future of pharmaceutical policy in the new European Commission2. The future is now: Beneluxai and other regional initiatives3. The political carte blanche...